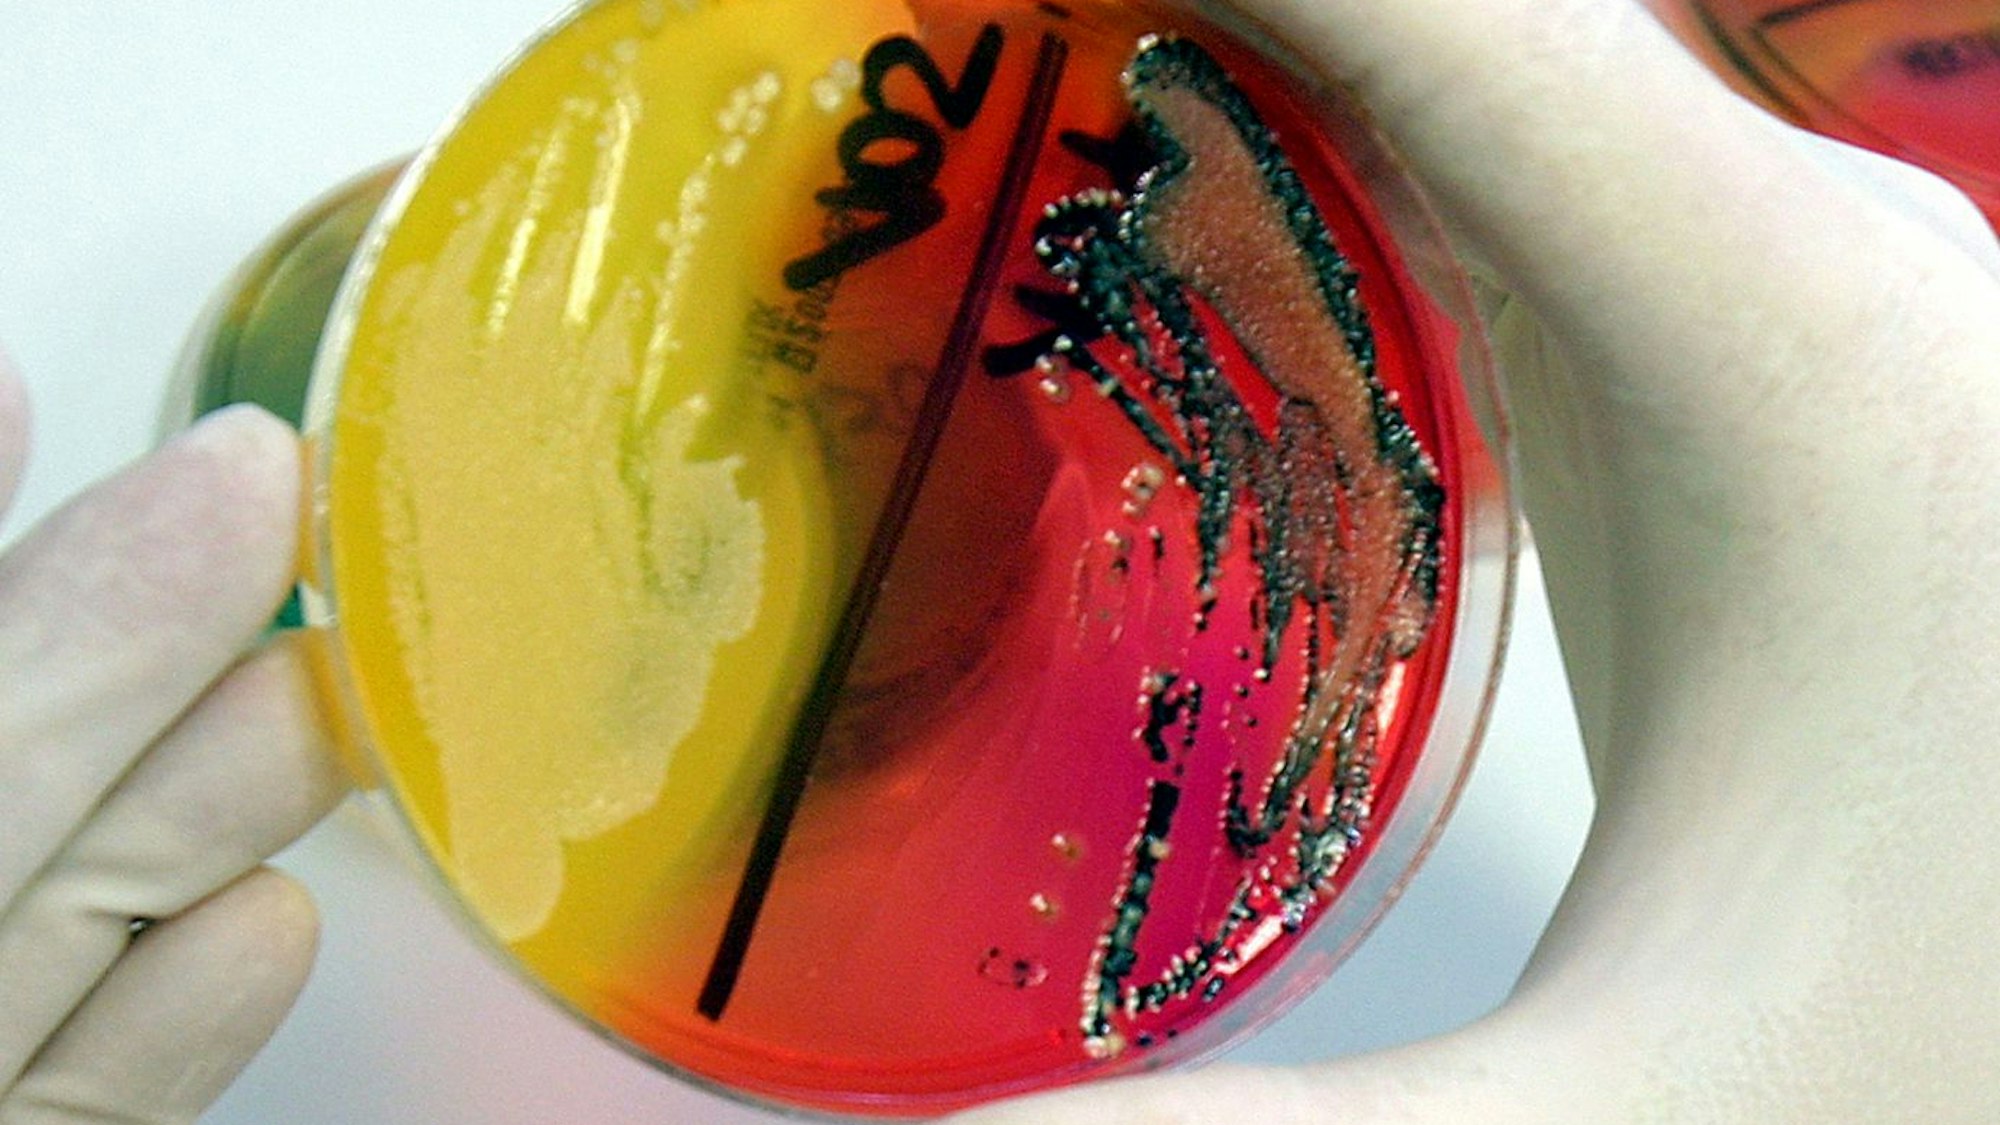

Vorsicht vor dem Verzehr dieser beliebten Süßigkeit. In einer Charge Halva mit Pistazien wurden Salmonellen nachgewiesen. Das Produkt wurde in mehreren Bundesländern verkauft. Worauf Kunden jetzt achten müssen.
Dringender RückrufSalmonellen in Süßspeise: Produkt in sieben Bundesländern verkauft
Copyright: picture-alliance/ dpa
Salmonellen schleichen sich schnell in Lebensmittel ein – vor allem in Nutztiererzeugnisse. Auf dem Symbolfoto, aufgenommen am 22.05.2007 in Fulda, zeigt eine Labor-Mitarbeiterin eine Petrischale mit einer Salmonellenkultur.
Aktualisiert
Köln. Salmonellen-Gefahr! Aktuell wird das Produkt „Alburj – Halva mit extra Pistazien 400g & 800g“ zurückgerufen. Der Verzehr könnte Ihrer Gesundheit schaden.
Weil in der Charge mit dem Mindesthaltbarkeitsdatum 07/2022 Salmonellen nachgewiesen wurden, hat die Kosebate GmbH die Charge zurückgerufen. Darüber berichtet unter anderem das bekannte Verbraucherschutz-Portal „produktwarnung.eu“.
Halva ist eine Süßwarenspezialität, die ursprünglich aus Indien, Iran, Pakistan und Zentralasien stammt. Die Grundmasse von Halva besteht in der Regel aus Ölsamen und Honig, Zucker oder Glukosesirup. Durch die Zugabe weiterer Zutaten wird die süße Speise verfeinert, sprich aromatisiert.
Rückruf wegen Salmonellen: Vorsicht bei diesem Halva-Produkt
Ursprünglich stammt Halva aus Indien, Iran, Pakistan und Zentralasien. Die orientalische Süßigkeit besteht aus gemahlenen Ölsamen (beispielsweise Sesam, Pistazien oder Sonnenblumenkernen) sowie Zucker und Honig. Es erfreut sich großer Beliebtheit und wird oft zu Tee serviert.
In einigen Produkten haben sich nun Bakterien gebildet und sorgen bei ihrem Verzehr für höchst unangenehme und schmerzhafte Symptome – gemeint sind Salmonellen. Welches Produkt ist genau betroffen?
- Produkt: Alburj – Halva mit extra Pistazien
- Verpackungseinheit: 400g und 800g
- Mindesthaltbarkeitsdatum: 09.07.2022
- Hersteller (Inverkehrbringer): Kosebate GmbH
Rückruf: Welche Beschwerden können Salmonellen verursachen?
Doch was sind Salmonellen überhaupt und was passiert, wenn man sie aus Versehen isst?
Salmonellen verursachen schwere Magen-Darm-Infektionen. Überwiegend entstehen diese durch den Verzehr von salmonellenhaltigen Lebensmitteln. Betroffen sind meistens Lebensmittel aus Nutztiererzeugnissen, also beispielsweise nicht ausreichend hoch erhitztes Rinder- oder Hähnchenfleisch, Eier oder eihaltige Produkte (in diesem Falle auch Halva).
Die stäbchenförmigen Bakterien sind unglaublich hitze- und kälteresistent: Laut „Apotheken-umschau.de“ widerstehen sie Temperaturen im Minusbereich und können erst nach mindestens zehn Minuten kochen bei über 70 Grad sterben. Sie vermehren sich am besten bei Temperaturen von 10 bis 47 Grad Celcius. Auch eigentlich nicht betroffene Lebensmittel können mit Salmonellen verseucht werden, wenn sie mit Oberflächen (beispielsweise Tiefkühltruhen) in Berührung kommen, welche vorher Kontakt mit salmonellenhaltigen Lebensmitteln hatten.
So können Sie sich vor einer Salmonellen-Infektion schützen
Doch wie äußert sich die Infektion? Üblich sind unerwartet einsetzender Durchfall, welcher mit Übelkeit, Erbrechen, manchmal auch Fieber, Kopf- und Bauchschmerzen und allgemeines Unwohlsein einhergeht. Die Symptome treten meist nach 12 bis 36 Stunden auf und dauern aber nur wenige Stunden an. Wichtig ist dabei die Frage, wie ich mich vor Salmonellen schützen kann:
- Händewaschen nach jedem Toilettengang und nach Kontakt mit tierischen Nutzerzeugnissen (beispielsweise beim Kochen)
- Lebensmittel, die anfällig für Salmonellen sind, sollten immer im Kühlschrank bei ungefähr 7 Grad Celsius gelagert werden
- Oberflächen (heiß) reinigen und das Abtauwasser von gefrorenem Geflügel oder Wild separat auffangen und entsorgen
- Nicht auf über 70 Grad Celsius erhitzbare Lebensmittel getrennt von rohen Lebensmitteln lagern
- Küchenutensilien (Schneidebretter, Messer, Spülschwämme etc.) gründlich und regelmäßig reinigen
Wo wurde „Alburj – Halva mit extra Pistazien“ verkauft?
Das mit Salmonellen belastete Halva ist in mehreren Bundesländern in Umlauf. Verbraucher sollten also wissen, ob sie das Lebensmittel gekauft haben. Laut „Lebensmittelwarnung.de“ sind folgende Bundesländer betroffen:
- Baden-Württemberg
- Bayern
- Hessen
- Niedersachsen
- Nordrhein-Westfalen
- Rheinland-Pfalz
- Sachsen-Anhalt
Wer „Alburj – Halva mit extra Pistazien“ mit dem oben angegebenen Daten besitzt, sollte den Verzehr des Produkts unbedingt unterlassen. Wenn es schon verzehrt wurde, sollte ein Arzt aufgesucht werden, um den Verdacht auf eine Infektion mit den Salmonellen-Bakterien auszuschließen. (sai)